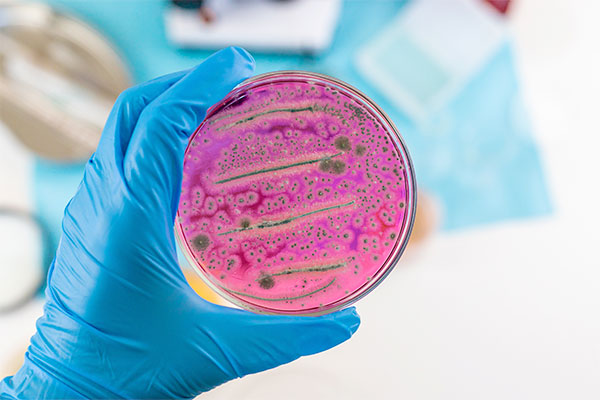
Imagen de Curso en Microbiología Clínica: Identificación de Patógenos y Antibiogramas

-
Areas Formativas
-
Sanidad
- Enfermería
- Fisioterapia
- Odontología
- Terapia Ocupacional
- Medicina
- TCAE
- Técnico en Farmacia y Parafarmacia
- Logopedia
- Celador
- Matronas
- Psicología Clínica
- Farmacia Hospitalaria
- Trabajo Social Sanitario
- Técnico Superior de Laboratorio Clínico
- Técnico Superior de Radiodiagnóstico
- Técnico Superior de Anatomía Patológica
- Técnico Superior en Documentación Sanitaria
- Técnico Superior en Dietética
- Técnico Superior en Higiene Bucodental
- Técnico Superior en Salud Ambiental
- Auxiliar Administrativo de Salud
- Administrativo de Salud
- Técnico de Gestión Sanitaria
- Técnico Superior de Administración Sanitaria
-
Educación
-
Justicia
-
Seguridad y Emergencias
-
Administración Pública
- Auxiliar Administrativo
- Administrativo
- Gestión Administrativa
- Técnicos de Administración General
- Administradores Civiles del Estado
- Gestión de la Administración Civil
- Técnicos de Gestión Pública
- Técnicos de Recursos Humanos
- Técnicos de Contratación Pública
- Técnicos de Gestión Económica
- Técnicos de Administración Local
-
Hacienda
-
Servicios Sociales
-
Instituciones Penitenciarias
-
Cultura
-
Transversales
- Igualdad en la Administración Pública
- Prevención de Riesgos Laborales
- Protección de Datos
- Administración Electrónica
- Violencia de Género
- Atención al Ciudadano
- Competencias Digitales
- Transparencia y Buen Gobierno
- Gestión Documental
- Firma Digital y Certificado Electrónico
- Seguridad de la Información
- Accesibilidad en la Administración
- Mediación y Resolución de Conflictos
- Calidad en la Administración Pública
- Trabajo en Equipo en la Administración
- Comunicación en la Administración Pública
- Soft Skills
- Empresas obligatorios
-
Sanidad
-
0